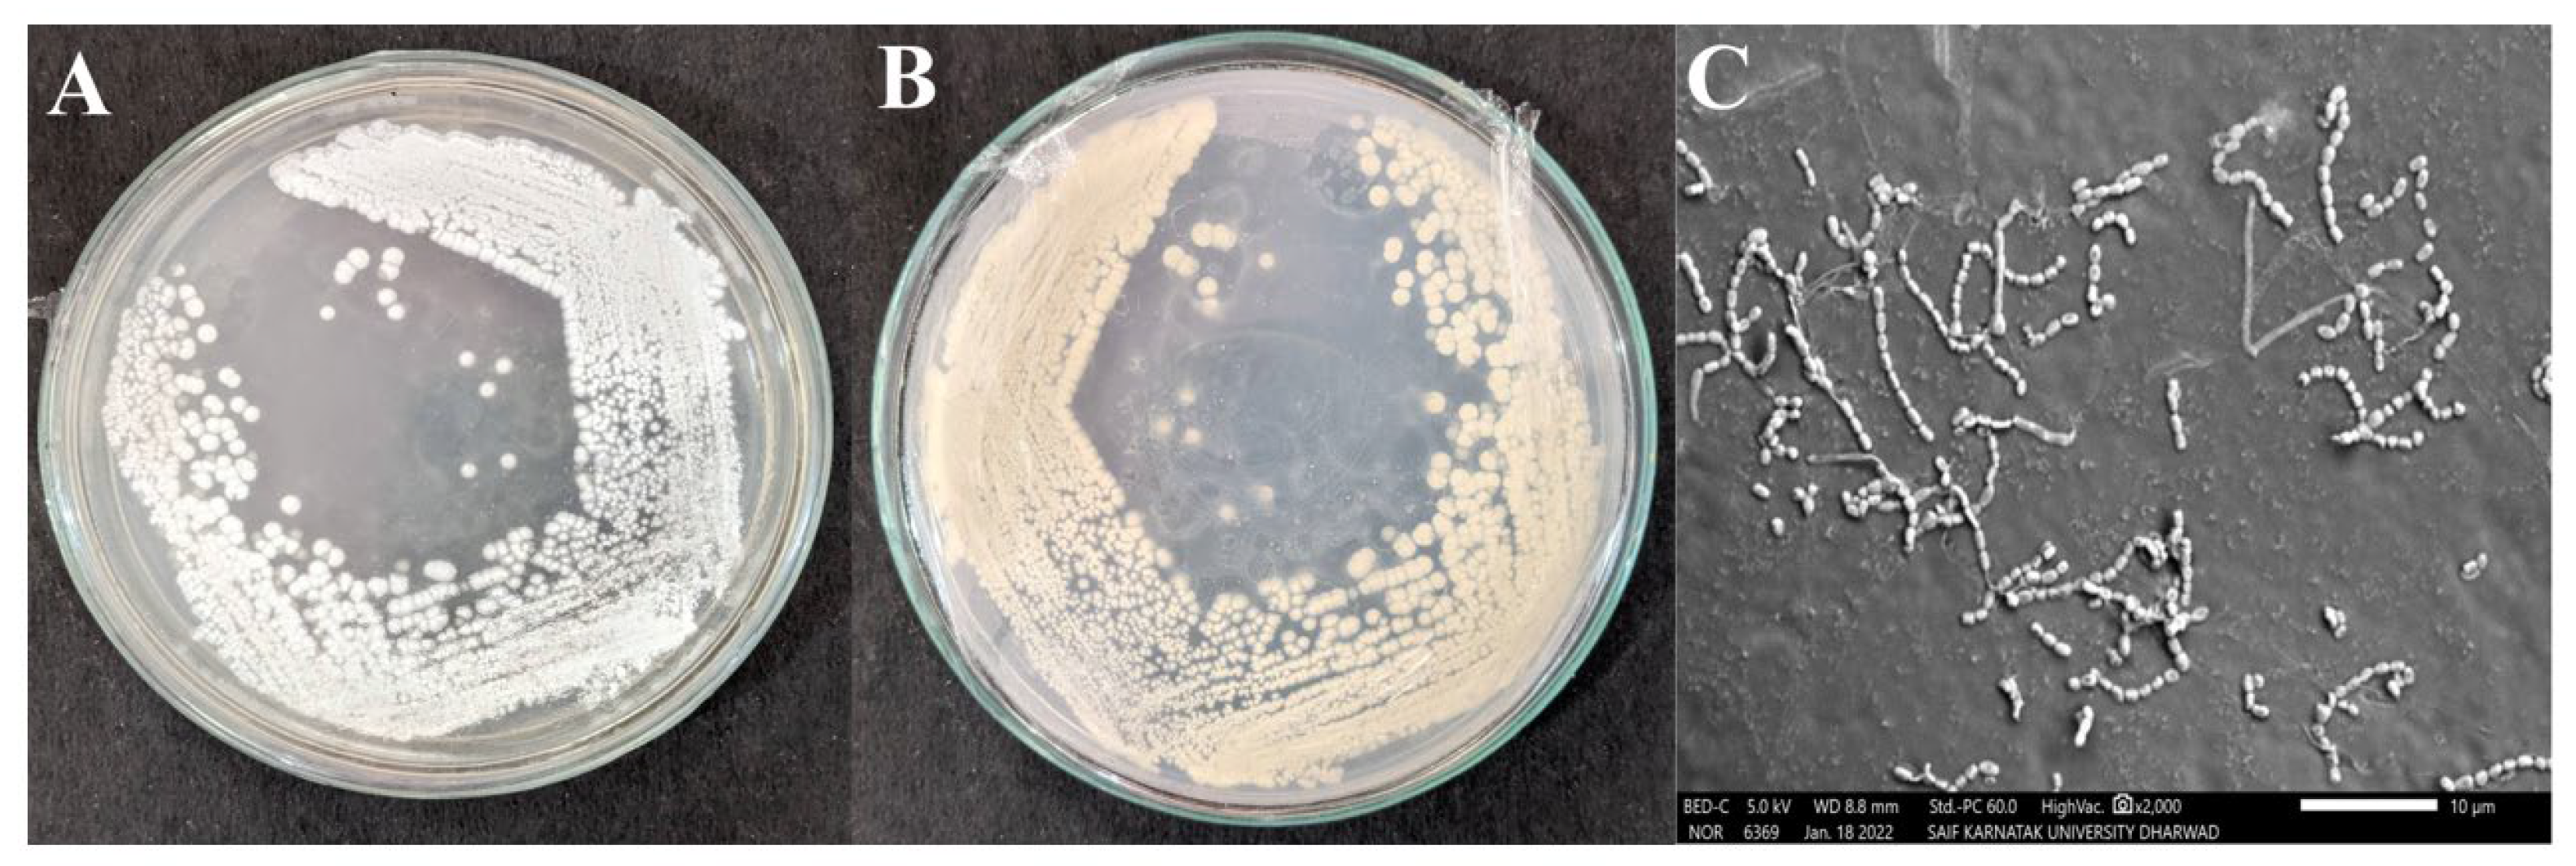
Antibiotics 12 01211 g002 Antibiotics 12 01211 g002

Isolation, Characterization of Pyraclostrobin Derived from Soil Actinomycete Streptomyces sp. HSN-01 and Its Antimicrobial and Anticancer Activity
Abstract
1. Introduction
2. Results
2.1. Isolation and Screening
2.2. Phylogenetic Analysis of Streptomyces sp. HSN-01
2.3. Morphological, Physiological, and Biochemical Characterizations of Streptomyces sp. HSN-01
2.4. Extraction of Secondary Metabolites
2.5. Purification of Ethyl Acetate Extract
2.6. Identification and Structure Elucidation
2.7. Antimicrobial Activity and MIC Assay
2.8. Evaluation of Anticancer Activity
3. Discussion
4. Materials and Methods
4.1. Pathogens Used in the Study
4.2. Isolation and Screening
4.3. Molecular Characterization
4.4. Morphological, Physiological, and Biochemical Characterizations of Streptomyces sp. HSN-01
4.5. Fermentation and Extraction
4.6. Purification and Characterization
4.7. Identification of the Compound
4.8. Antimicrobial Activity and MIC Assay
4.9. Evaluation of Anticancer Activity by MTT Assay
4.10. Statistical Analysis
5. Conclusions
Author Contributions
Funding
Institutional Review Board Statement
Informed Consent Statement
Data Availability Statement
Acknowledgments
Conflicts of Interest
References
- Niazi, S.K.; Basavarajappa, D.S.; Kumaraswamy, S.H.; Bepari, A.; Hiremath, H.; Nagaraja, S.K.; Rudrappa, M.; Hugar, A.; Cordero, M.A.W.; Nayaka, S. GC-MS Based characterization, antibacterial, antifungal and anti-oncogenic activity of ethyl acetate extract of Aspergillus niger strain AK-6 isolated from rhizospheric soil. Curr. Issues Mol. Biol. 2023, 45, 3733–3756. [Google Scholar] [CrossRef] [PubMed]
- Shashiraj, K.N.; Nayaka, S.; Kumar, R.S.; Kantli, G.B.; Basavarajappa, D.S.; Gunagambhire, P.V.; Almansour, A.I.; Perumal, K. Rotheca serrata flower bud extract mediated bio-friendly preparation of silver nanoparticles: Their characterizations, anticancer, and apoptosis inducing ability against pancreatic ductal adenocarcinoma cell line. Processes 2023, 11, 893. [Google Scholar] [CrossRef]
- Alam, K.; Mazumder, A.; Sikdar, S.; Zhao, Y.-M.; Hao, J.; Song, C.; Wang, Y.; Sarkar, R.; Islam, S.; Zhang, Y.; et al. Streptomyces: The Biofactory of secondary metabolites. Front. Microbiol. 2022, 13, 968053. [Google Scholar] [CrossRef] [PubMed]
- Rammali, S.; Hilali, L.; Dari, K.; Bencharki, B.; Rahim, A.; Timinouni, M.; Gaboune, F.; El Aalaoui, M.; Khattabi, A. Antimicrobial and antioxidant activities of Streptomyces species from soils of three different cold sites in the fez-meknes region Morocco. Sci. Rep. 2022, 12, 17233. [Google Scholar] [CrossRef]
- Chanthasena, P.; Hua, Y.; Rosyidah, A.; Pathom-Aree, W.; Limphirat, W.; Nantapong, N. Isolation and identification of bioactive compounds from Streptomyces actinomycinicus PJ85 and their in vitro antimicrobial activities against methicillin-resistant Staphylococcus aureus. Antibiotics 2022, 11, 1797. [Google Scholar] [CrossRef]
- Chakraborty, B.; Kumar, R.S.; Almansour, A.I.; Perumal, K.; Nayaka, S.; Brindhadevi, K. Streptomyces filamentosus strain KS17 isolated from microbiologically unexplored marine ecosystems exhibited a broad spectrum of antimicrobial activity against human pathogens. Process Biochem. 2022, 117, 42–52. [Google Scholar] [CrossRef]
- Bhat, M.P.; Nayaka, S.; Kumar, R.S. A Swamp forest Streptomyces sp. strain KF15 with broad spectrum antifungal activity against chilli pathogens exhibits anticancer activity on HeLa cells. Arch. Microbiol. 2022, 204, 540. [Google Scholar] [CrossRef]
- Chen, Z.; Xie, H.; Hu, M.; Huang, T.; Hu, Y.; Sang, N.; Zhao, Y. Recent progress in treatment of hepatocellular carcinoma. Am. J. Cancer Res. Sep. 2020, 10, 2993–3036. [Google Scholar]
- Kashif, M.; Kim, D.; Kim, G. In Vitro antiproliferative and apoptosis inducing effect of a methanolic extract of Azadirachta indica oil on selected cancerous and noncancerous cell lines. Asian. Pac. J. Trop. Med. 2018, 11, 555. [Google Scholar] [CrossRef]
- Acharya, S.K. Epidemiology of hepatocellular carcinoma in India. J. Clin. Exp. Hepatol. 2014, 4, S27–S33. [Google Scholar] [CrossRef]
- Thusyanthan, J.; Wickramaratne, N.S.; Senathilake, K.S.; Rajagopalan, U.; Tennekoon, K.H.; Thabrew, I.; Samarakoon, S.R. Cytotoxicity against human hepatocellular carcinoma (HepG2) cells and anti-oxidant activity of selected endemic or medicinal plants in Sri Lanka. Adv. Pharmacol. Pharm. Sci. 2022, 2022, 6407688. [Google Scholar] [CrossRef] [PubMed]
- Peng, J.; Zhang, Q.; Jiang, X.; Ma, L.; Long, T.; Cheng, Z.; Zhang, C.; Zhu, Y. New piericidin derivatives from the marine-derived Streptomyces sp. SCSIO 40063 with cytotoxic activity. Nat. Prod. Res. 2022, 36, 2458–2464. [Google Scholar] [CrossRef] [PubMed]
- Ibrahim, W.M.; Olama, Z.A.; Abou-elela, G.M.; Ramadan, H.S.; Hegazy, G.E.; El Badan, D.E.S. Exploring the antimicrobial, antiviral, antioxidant, and antitumor potentials of marine Streptomyces tunisiensis W4MT573222 pigment isolated from Abu-Qir sediments, Egypt. Microb. Cell Fact. 2023, 22, 94. [Google Scholar] [CrossRef]
- Osama, N.; Bakeer, W.; Raslan, M.; Soliman, H.A.; Abdelmohsen, U.R.; Sebak, M. Anti-cancer and antimicrobial potential of five soil Streptomycetes: A metabolomics-based study. R. Soc. Open Sci. 2022, 9, 211509. [Google Scholar] [CrossRef] [PubMed]
- Rudrappa, M.; Nayaka, S.; Kumar, R.S. In Silico molecular docking approach of melanin against melanoma causing MITF proteins and anticancer, oxidation–reduction, photoprotection, and drug-binding affinity properties of extracted melanin from Streptomyces sp. strain MR28. Appl. Biochem. Biotechnol. 2023, 195, 4368–4386. [Google Scholar] [CrossRef] [PubMed]
- Gyldenkærne, S.; Secher, B.J.; Nordbo, E. Ground deposit of pesticides in relation to the cereal canopy density. Pest. Manag. Sci. 1999, 55, 1210–1216. [Google Scholar] [CrossRef]
- Ait Assou, S.; Anissi, J.; Sendide, K.; El Hassouni, M. Diversity and antimicrobial activities of actinobacteria isolated from mining soils in Midelt Region, Morocco. Sci. World J. 2023, 2023, 6106673. [Google Scholar] [CrossRef]
- Sarika, K.; Sampath, G.; Kaveriyappan Govindarajan, R.; Ameen, F.; Alwakeel, S.; Al Gwaiz, H.I.; Raja Komuraiah, T.; Ravi, G. Antimicrobial and antifungal activity of soil actinomycetes isolated from coal mine sites. Saudi J. Biol. Sci. 2021, 28, 3553–3558. [Google Scholar] [CrossRef]
- Sapkota, A.; Thapa, A.; Budhathoki, A.; Sainju, M.; Shrestha, P.; Aryal, S. Isolation, characterization, and screening of antimicrobial-producing actinomycetes from soil samples. Int. J. Microbiol. 2020, 2020, 2716584. [Google Scholar] [CrossRef]
- Zainal Abidin, Z.A.; Abdul Malek, N.; Zainuddin, Z.; Chowdhury, A.J.K. Selective isolation and antagonistic activity of actinomycetes from mangrove forest of Pahang, Malaysia. Front. Life Sci. 2016, 9, 24–31. [Google Scholar] [CrossRef]
- Kumar, V.; Naik, B.; Gusain, O.; Bisht, G.S. An Actinomycete isolate from solitary wasp mud nest having strong antibacterial activity and kills the candida cells due to the shrinkage and the cytosolic loss. Front. Microbiol. 2014, 5, 446. [Google Scholar] [CrossRef] [PubMed]
- Khosravi Babadi, Z.; Ebrahimipour, G.; Wink, J.; Narmani, A.; Risdian, C. Isolation and identification of Streptomyces sp. Act4Zk, a good producer of staurosporine and some derivatives. Lett. Appl. Microbiol. 2021, 72, 206–218. [Google Scholar] [CrossRef] [PubMed]
- Rudrappa, M.; Kumar, M.S.; Kumar, R.S.; Almansour, A.I.; Perumal, K.; Nayaka, S. Bioproduction, purification and physicochemical characterization of melanin from Streptomyces sp. strain MR28. Microbiol. Res. 2022, 263, 127130. [Google Scholar] [CrossRef]
- Chakraborty, B.; Kumar, R.S.; Almansour, A.I.; Gunasekaran, P.; Nayaka, S. Bioprospection and secondary metabolites profiling of marine Streptomyces levis strain KS46. Saudi J. Biol. Sci. 2022, 29, 667–679. [Google Scholar] [CrossRef]
- Kamat, N.; Velho-Pereira, S. Antimicrobial screening of actinobacteria using a modified cross-streak method. Indian J. Pharm. Sci. 2011, 73, 223. [Google Scholar] [CrossRef] [PubMed]
- Williston, E.H.; Zia-Walrath, P.; Youmans, G.P. Plate methods for testing antibiotic activity of actinomycetes against virulent human type Tubercle Bacilli. J. Bacteriol. 1947, 54, 563–568. [Google Scholar] [CrossRef] [PubMed]
- Kumar, S.; Kannabiran, K. Antifungal activity of Streptomyces VITSVK5 spp. against drug resistant Aspergillus clinical isolates from pulmonary tuberculosis patients. J. Mycol. Médicale 2010, 20, 101–107. [Google Scholar] [CrossRef]
- Rizk, M.; Rizk, M.; Rahman, T.A.; Metwally, H. Screening of antagonistic activity in different Streptomyces species against some pathogenic microorganisms. J. Biol. Sci. 2007, 7, 1418–1423. [Google Scholar] [CrossRef]
- Kim, K.-R.; Kim, T.-J.; Suh, J.-W. The gene cluster for spectinomycin biosynthesis and the aminoglycoside-resistance function of SpcM in Streptomyces spectabilis. Curr. Microbiol. 2008, 57, 371–374. [Google Scholar] [CrossRef]
- Selvakumar, J.; Chandrasekaran, S.; Vaithilingam, M. Bio prospecting of marine-derived Streptomyces spectabilis VITJS10 and exploring its cytotoxicity against human liver cancer cell lines. Pharmacogn. Mag. 2015, 11, 469. [Google Scholar] [CrossRef]
- Muthuraj, R.; Meghashyama, P.B.; Dhanyakumara, S.B.; Halaswamy, H.M.; Shashiraj, K.N.; Chakraborty, B.; Pallavi, S.S.; Sreenivasa, N. Isolation, identification and characterization of antimicrobial activity exhibiting actinomycete Streptomyces paradoxus strain KUASN-7 from soil. Int. J. Curr. Microbiol. App. Sci. 2021, 10, 164–176. [Google Scholar] [CrossRef]
- Cox, M.J.; Cookson, W.O.C.M.; Moffatt, M.F. Sequencing the human microbiome in health and disease. Hum. Mol. Genet. 2013, 22, R88–R94. [Google Scholar] [CrossRef] [PubMed]
- Ravel, J.; Wellington, E.M.H.; Hill, R.T. Interspecific transfer of Streptomyces giant linear plasmids in sterile amended soil microcosms. Appl. Environ. Microbiol. 2000, 66, 529–534. [Google Scholar] [CrossRef] [PubMed]
- Almalki, M.A. Isolation and characterization of polyketide drug molecule from Streptomyces species with antimicrobial activity against clinical pathogens. J. Infect. Public Health 2020, 13, 125–130. [Google Scholar] [CrossRef]
- Siddharth, S.; Vittal, R.R.; Wink, J.; Steinert, M. Diversity and bioactive potential of actinobacteria from unexplored regions of Western Ghats, India. Microorganisms 2020, 8, 225. [Google Scholar] [CrossRef] [PubMed]
- Thakur, D.; Bora, T.C.; Bordoloi, G.N.; Mazumdar, S. Influence of nutrition and culturing conditions for optimum growth and antimicrobial metabolite production by Streptomyces sp. 201. J. Mycol. Médicale 2009, 19, 161–167. [Google Scholar] [CrossRef]
- Subathra Devi, C.; Saini, A.; Rastogi, S.; Jemimah Naine, S.; Mohanasrinivasan, V. Strain improvement and optimization studies for enhanced production of erythromycin in bagasse based medium using Saccharopolyspora erythraea MTCC 1103. 3 Biotech 2015, 5, 23–31. [Google Scholar] [CrossRef]
- Ser, H.-L.; Palanisamy, U.D.; Yin, W.-F.; Chan, K.-G.; Goh, B.-H.; Lee, L.-H. Streptomyces malaysiense sp. nov.: A Novel malaysian mangrove soil actinobacterium with antioxidative activity and cytotoxic potential against human cancer cell lines. Sci. Rep. 2016, 6, 24247. [Google Scholar] [CrossRef]
- Ambarwati, A.; Wahyuono, S.; Moeljopawiro, S.; Yuwono, T. Antimicrobial activity of ethyl acetate extracts of Streptomyces sp. CRB46 and the prediction of their bioactive compounds chemical structure. Biodiversitas 2020, 21, 3380–3390. [Google Scholar] [CrossRef]
- Alqahtani, S.S.; Moni, S.S.; Sultan, M.H.; Ali Bakkari, M.; Madkhali, O.A.; Alshahrani, S.; Makeen, H.A.; Joseph Menachery, S.; Ur Rehman, Z.; Shamsher Alam, M.; et al. Potential bioactive secondary metabolites of Actinomycetes sp. isolated from rocky soils of the heritage village Rijal Alma, Saudi Arabia. Arab. J. Chem. 2022, 15, 103793. [Google Scholar] [CrossRef]
- Mathur, N.; Paliwal, A.; Kumar, M.; Sharma, P.; Bhatnagar, P. Antimicrobial activity of actinomycetes strain isolated from soils of unusual ecological niches. Int. J. Chem. Sci. 2012, 10, 2237–2247. [Google Scholar]
- Han, L.; Wu, Q.; Wu, X. Dissipation and residues of pyraclostrobin in Rosa roxburghii and soil under field conditions. Foods 2022, 11, 669. [Google Scholar] [CrossRef] [PubMed]
- Anastassiades, M.; Lehotay, S.J.; Štajnbaher, D.; Schenck, F.J. Fast and easy multiresidue method employing acetonitrile extraction/partitioning and “Dispersive solid-phase extraction” for the determination of pesticide residues in produce. J. AOAC Int. 2003, 86, 412–431. [Google Scholar] [CrossRef] [PubMed]
- Sharma, V.; Kaur, R.; Salwan, R. Streptomyces: Host for refactoring of diverse bioactive secondary metabolites. 3 Biotech 2021, 11, 340. [Google Scholar] [CrossRef]
- Zabala, D.; Braña, A.F.; Flórez, A.B.; Salas, J.A.; Méndez, C. Engineering precursor metabolite pools for increasing production of antitumor mithramycins in Streptomyces argillaceus. Metab. Eng. 2013, 20, 187–197. [Google Scholar] [CrossRef]
- Sharma, V.; Sharma, A.; Malannavar, A.B.; Salwan, R. Molecular aspects of biocontrol species of Streptomyces in agricultural crops. In Molecular Aspects of Plant Beneficial Microbes in Agriculture; Elsevier: Amsterdam, The Netherlands, 2020; pp. 89–109. ISBN 978-0-12-818469-1. [Google Scholar]
- Sambamurthy, K.; Ellaiah, P. A new Streptomycete producing neomycin (B&C) complex- S. marinensis (Part I). Hindustan Antibiot. Bull. 1974, 17, 24–28. [Google Scholar]
- Beran, M.; Zima, J. Determination of monensins A and B in the fermentation broth of Streptomyces cinnamonensis by high performance liquid chromatography. Chromatographia 1993, 35, 206–208. [Google Scholar] [CrossRef]
- Dhanasekaran, D.; Paneerselvam, A.; Thajuddin, N. An antifungal compound: 4’phenyl-1-napthyl-phenylacetamide from Streptomyces sp. DBTB16. Facta Univ. Ser. Med. Biol. 2008, 15, 7–12. [Google Scholar]
- Selim, R.M.; Shaaban, M.; Hamdy, A.A.; Abou Zeid, A.A.; Ata, A. Viscosine: A New microbial flavonoid from marine-derived, Streptomyces sp. RMS518F. Vietnam. J. Chem. 2019, 57, 288–295. [Google Scholar] [CrossRef]
- Reygaert, W. An Overview of the antimicrobial resistance mechanisms of bacteria. AIMS Microbiol. 2018, 4, 482–501. [Google Scholar] [CrossRef]
- Rateb, M.E.; Houssen, W.E.; Arnold, M.; Abdelrahman, M.H.; Deng, H.; Harrison, W.T.A.; Okoro, C.K.; Asenjo, J.A.; Andrews, B.A.; Ferguson, G.; et al. Chaxamycins A–D, Bioactive ansamycins from a hyper-arid desert Streptomyces sp. J. Nat. Prod. 2011, 74, 1491–1499. [Google Scholar] [CrossRef] [PubMed]
- Ma, A.; Jiang, K.; Chen, B.; Chen, S.; Qi, X.; Lu, H.; Liu, J.; Zhou, X.; Gao, T.; Li, J.; et al. Evaluation of the anticarcinogenic potential of the endophyte, Streptomyces sp. LRE541 isolated from Lilium davidii var. unicolor (Hoog) cotton. Microb. Cell Fact. 2021, 20, 217. [Google Scholar] [CrossRef] [PubMed]

| Actinomycete Isolates | B. cereus | S. aureus | E. coli | P. aeruginosa | S. flexneri | C. glabrata |
|---|---|---|---|---|---|---|
| HM-01 | +++ | +++ | − | + | + | + |
| HM-02 | − | ++ | − | +++ | − | ++ |
| HM-03 | − | + | ++ | + | +++ | − |
| HM-04 | − | +++ | − | − | ++ | − |
| HM-05 | ++ | − | + | ++ | − | + |
| HM-06 | − | − | +++ | − | + | ++ |
| HM-07 | ++ | +++ | − | − | − | ++ |
| HSN-01 | +++ | ++ | +++ | +++ | ++ | +++ |
| HSN-02 | ++ | + | − | ++ | +++ | ++ |
| HSN-03 | − | ++ | − | +++ | − | − |
| HSN-04 | ++ | − | ++ | + | + | − |
| HSN-05 | +++ | + | ++ | − | + | ++ |
| HSN-06 | + | ++ | − | + | +++ | − |
| HS-01 | +++ | − | − | ++ | + | − |
| HS-02 | − | + | − | ++ | − | ++ |
| HS-03 | ++ | − | + | − | + | − |
| HS-04 | + | +++ | − | − | ++ | +++ |
| HS-05 | +++ | − | + | ++ | − | + |
| HS-06 | − | − | ++ | − | +++ | − |
| HS-08 | + | − | ++ | + | +++ | + |
| HS-09 | ++ | − | − | ++ | − | − |
| Morphological Characterizations | |||
|---|---|---|---|
| Colony characteristics | Aerial mycelia | Substrate mycelia | |
| Color | Whitish | Pale yellow | |
| Gram staining | Gram-positive | ||
| Margin | Filiform | ||
| Elevation | Elevated | ||
| Texture | Powdery and dry | ||
| Pigmentation | Yellow colored pigment | ||
| Physiological Characterizations | |||
| Growth at different temperature | Growth in different pH | ||
| 20 °C | − | pH 5.0 | − |
| 25 °C | w | pH 6.0 | − |
| 30 °C | +++ | pH 7.0 | +++ |
| 35 °C | ++ | pH 8.0 | w |
| 40 °C | w | pH 9.0 | − |
| 45 °C | w | pH 10.0 | − |
| Tests | Results | Tests | Results |
|---|---|---|---|
| BETA-XYLOSIDASE | + | D-MANNITOL | − |
| L-Lysine-ARYLAMIDASE | + | D-MANNOSE | − |
| L-Aspartate ARYLAMIDASE | + | D-MELEZITOSE | − |
| Leucine ARYLAMIDASE | + | N-ACETYL-D-GLUCOSAMINE | − |
| Phenylalanine ARYLAMIDASE | + | PALATINOSE | − |
| L-Proline ARYLAMIDASE | − | L-RHAMNOSE | − |
| BETA-GALACTOSIDASE | − | BETA-GLUCOSIDASE | + |
| L-Pyrrolidonyl-ARYLAMIDASE | + | BETA-MANNOSIDASE | − |
| ALPHA-GALACTOSIDASE | − | PHOSPHORYL CHOLINE | − |
| Alanine ARYLAMIDASE | + | PYRUVATE | + |
| Tyrosine ARYLAMIDASE | + | ALPHA-GLUCOSIDASE | − |
| BETA-N-ACETYL-GLUCOSAMINIDASE | + | D-TAGATOSE | − |
| Ala-Phe-Pro ARYLAMIDASE | + | D-TREHALOSE | − |
| CYCLODEXTRIN | − | INULIN | − |
| D-GALACTOSE | − | D-GLUCOSE | + |
| GLYCOGEN | − | D-RIBOSE | − |
| myo-INOSITOL | − | PUTRESCINE assimilation | − |
| METHYL-A-D-GLUCOPYRANOSIDE acidification | − | GROWTH IN 6.5% NaCl | − |
| ELLMAN | − | KANAMYCIN RESISTANCE | − |
| METHYL-D-XYLOSIDE | − | OLEANDOMYCIN RESISTANCE | − |
| ALPHA-MANNOSIDASE | − | ESCULIN hydrolysis | + |
| MALTOTRIOSE | − | TETRAZOLIUM RED | − |
| Glycine ARYLAMIDASE | − | POLYMIXIN-B RESISTANCE | − |
| Pathogens | MIC (µg/mL) | Standards (µg/mL) | DMSO (Control) |
|---|---|---|---|
| B. cereus | 3.12 | 0.8 | − |
| S. aureus | 1.6 | 0.9 | − |
| E. coli | 12.5 | 1.6 | − |
| P. aeruginosa | 25 | 3.12 | − |
| S. flexneri | 6.25 | 1.6 | − |
| C. glabrata | 3.12 | 0.8 | − |
Disclaimer/Publisher’s Note: The statements, opinions and data contained in all publications are solely those of the individual author(s) and contributor(s) and not of MDPI and/or the editor(s). MDPI and/or the editor(s) disclaim responsibility for any injury to people or property resulting from any ideas, methods, instructions or products referred to in the content. |
© 2023 by the authors. Licensee MDPI, Basel, Switzerland. This article is an open access article distributed under the terms and conditions of the Creative Commons Attribution (CC BY) license (https://creativecommons.org/licenses/by/4.0/).
Share and Cite
Math, H.H.; Nayaka, S.; Rudrappa, M.; Kumar, R.S.; Almansour, A.I.; Perumal, K.; Kantli, G.B. Isolation, Characterization of Pyraclostrobin Derived from Soil Actinomycete Streptomyces sp. HSN-01 and Its Antimicrobial and Anticancer Activity. Antibiotics 2023, 12, 1211. https://doi.org/10.3390/antibiotics12071211
Math HH, Nayaka S, Rudrappa M, Kumar RS, Almansour AI, Perumal K, Kantli GB. Isolation, Characterization of Pyraclostrobin Derived from Soil Actinomycete Streptomyces sp. HSN-01 and Its Antimicrobial and Anticancer Activity. Antibiotics. 2023; 12(7):1211. https://doi.org/10.3390/antibiotics12071211
Chicago/Turabian StyleMath, Halaswamy Hire, Sreenivasa Nayaka, Muthuraj Rudrappa, Raju Suresh Kumar, Abdulrahman I. Almansour, Karthikeyan Perumal, and Girish Babu Kantli. 2023. "Isolation, Characterization of Pyraclostrobin Derived from Soil Actinomycete Streptomyces sp. HSN-01 and Its Antimicrobial and Anticancer Activity" Antibiotics 12, no. 7: 1211. https://doi.org/10.3390/antibiotics12071211
APA StyleMath, H. H., Nayaka, S., Rudrappa, M., Kumar, R. S., Almansour, A. I., Perumal, K., & Kantli, G. B. (2023). Isolation, Characterization of Pyraclostrobin Derived from Soil Actinomycete Streptomyces sp. HSN-01 and Its Antimicrobial and Anticancer Activity. Antibiotics, 12(7), 1211. https://doi.org/10.3390/antibiotics12071211

